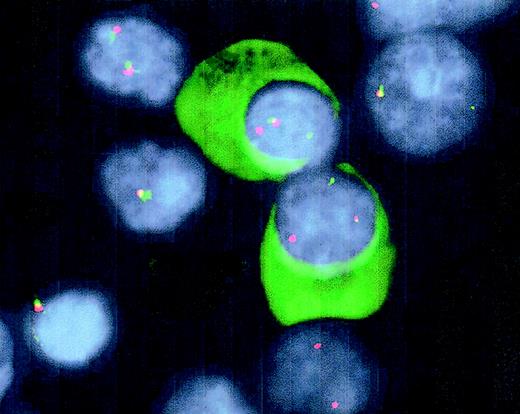
Fig. 1. Detection of t(14q32) by double-color FISH and Ig-light-chain staining in interphase plasma cells. / Cytospin slides from BM samples were fixed in 10% acetic acid solution in ethanol, followed by dehydration, denaturation (70% formamide), and dehydration. After hybridization of the probes overnight at 37°C, immunoglobulins were stained using FITC-conjugated goat anti-human light-chain antibodies to positively identify plasma cells. The IgH2 and C-α probes were detected following standard avidine-FITC and CY3 staining. The slides were mounted with antifade medium containing DAPI. Fusion signals of the probes indicate nontranslocated IgH loci, whereas split signals reflect a translocation of the IgH locus.

Fonseca et al1 have recently reported a high frequency (46%) of IgH translocations to occur in monoclonal gammopathy of undetermined significance. As this frequency seems to approach the reported frequencies in multiple myeloma (MM; 60%-70%),2 3 it was suggested that IgH translocations represent early cytogenetic events in plasma cell discrasias and are likely of pathogenetic importance. They have plasma cells positively identified by staining interphase cells with AMCA-conjugated (blue fluorescent) anti–light chain antibodies, followed by denaturation and probing with green- and red-labeled probes, thus obviating the need to culture or purify plasma cells in vitro. Here we have furthered this approach by modifying the procedure to a double-color immunofluorescence in situ hybridization (immuno-FISH), where fluorescein isothiocyanate (FITC) is used both for Ig staining and probing, and we found near ubiquity of t(14q32) in MM, confirming the notion of IgH translocations being early pathogenic events.
Bone marrow (BM) samples (57) were obtained from patients with MM at the time of diagnosis (47) or during follow-up, and cytospin slides were prepared. t(14q32) was detected using a set of probes spanning the IgH locus, labeled with either biotin or digoxigenin, as we described earlier.4 For light chain–specific detection of the plasma cells, FITC-conjugated antibodies directed against human κ or λ were used (SBA, Birmingham, AL). For each sample, we analyzed 100 plasma cells using CytoVision Applied Imaging software (DSS Imagetech, New Delhi, India).
Of 47 patients studied at diagnosis, 45 were evaluable. Of these samples, 43 (96%) carried a t(14q32). In the majority of cases, the translocation was found in all plasma cells, whereas in one-third of the patients, the percentage of plasma cells having an identifiable t(14q32) varied from 14% to 82% (mean, 62%). In 10 patients at follow-up, t(14q32) was essentially as frequent (data not shown); in this situation, the presence of as low as 0.1% plasma cells in BM still did allow positive identification of the t(14q32).
This modified FISH technique to detect IgH translocations in well-defined cells is restricted to the 3 usual fluorescent markers (FITC, cyanine 3.18 [CY3], and diamidinophenolindole [DAPI]) and is easily applicable on normal fluorescent microscopes. Cytoplasmic staining with an FITC-conjugated antibody allows for positive identification of plasma cells, whereas DAPI-mediated morphologic discrimination allows for probing with the same FITC signal in nuclear localization (Figure 1). Because of the sensitivity of the technique, it may be applied for follow-up of patients during treatment regimens. Furthermore, the technique may be applied for detection of partner chromosomes of t(14q32) that, as well as other molecular characteristics, have been suggested to have clinical2,5,6 and pathophysiologic7 relevance for a molecular subdivision of MM.
Detection of t(14q32) by double-color FISH and Ig-light-chain staining in interphase plasma cells.
Cytospin slides from BM samples were fixed in 10% acetic acid solution in ethanol, followed by dehydration, denaturation (70% formamide), and dehydration. After hybridization of the probes overnight at 37°C, immunoglobulins were stained using FITC-conjugated goat anti-human light-chain antibodies to positively identify plasma cells. The IgH2 and C-α probes were detected following standard avidine-FITC and CY3 staining. The slides were mounted with antifade medium containing DAPI. Fusion signals of the probes indicate nontranslocated IgH loci, whereas split signals reflect a translocation of the IgH locus.
Detection of t(14q32) by double-color FISH and Ig-light-chain staining in interphase plasma cells.
Cytospin slides from BM samples were fixed in 10% acetic acid solution in ethanol, followed by dehydration, denaturation (70% formamide), and dehydration. After hybridization of the probes overnight at 37°C, immunoglobulins were stained using FITC-conjugated goat anti-human light-chain antibodies to positively identify plasma cells. The IgH2 and C-α probes were detected following standard avidine-FITC and CY3 staining. The slides were mounted with antifade medium containing DAPI. Fusion signals of the probes indicate nontranslocated IgH loci, whereas split signals reflect a translocation of the IgH locus.
Earlier, we reported t(14q32) to occur in up to 95% of human myeloma cell lines.4 Now, the frequency of t(14q32) in MM patients at diagnosis seems to be as high, indicating that findings in cell lines do not point to an in vitro artifact but rather indicate that IgH translocations are an early pathogenic event in MM.
Supported by grant UU 2000-2278 of the Dutch Cancer Society KWF

This feature is available to Subscribers Only
Sign In or Create an Account Close Modal